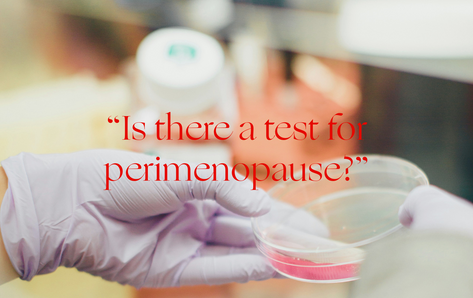

Bone Health After Menopause: What Every Woman Should Know
Stronger bones start here.
Ask An OB/GYN: “Is there a test to confirm if I am in perimenopause?”
Dr. Jila has a few things to say.

Ask An OB/GYN: “How do I know I'm definitely in perimenopause?”
Dr. Jila explains it all.

Ask an OB/GYN: “Should I try HRT in perimenopause?”
Hear what Dr. Jila has to say about HRT in peri versus menopause.

Your Ultimate Perimenopause Toolkit
Favorite solutions (with exclusive discounts!) for some of your most common symptoms.

What to eat to prevent hair loss in midlife
Learn the vitamins and nutrients that can help block too-high levels of a hormone linked to hair loss.

Ask an OB/GYN: “How can I protect my hair as I age?”
Our Medical Advisor talks inflammation and how it contributes to hair loss.

Ask an OB/GYN: “Can I use vaginal moisturizer with vaginal estrogen?”
Is it overkill, or can you combine the two? Our Medical Advisor delivers the deets.

5 Expert Tips for Silicone Eye Patches
Meet a versatile and effective tool for aging well around the eyes.

Ask an Esthetician: “How should prep my skin for winter?”
Skin changing as you age? Here's what to know as colder weather heads our way.

Your Vulvar Health: Essential Tips in Perimenopause + Beyond
6 ways to thrive in your menopause transition

10 Expert Tips for Thriving in Peri
Advice from a Women's Health Nurse Practitioner on how to evolve when what was working no longer works.

Ask an Obesity Doctor: "I am in perimenopause. Can I prevent weight gain in menopause?"
Dr. Katherine Saunders, a leading expert in Obesity Medicine, has your answer.

6 Foods to Help You Beat Perimenopause Bloating
Looking for relief? What you eat can make a huge difference.

5 Things I Wish I’d Known About Hormone Replacement Therapy
Perimenopause feeling like an uphill battle? Here's what to know to feel less alone.

5 Common Questions About Irregular Periods
Periods weird in perimenopause? Get answers from our resident women's health nurse.

Ask a Doctor: "What the heck is perimenopause?"
Dr. Somi Javaid has the answer to one of your most frequently asked questions.